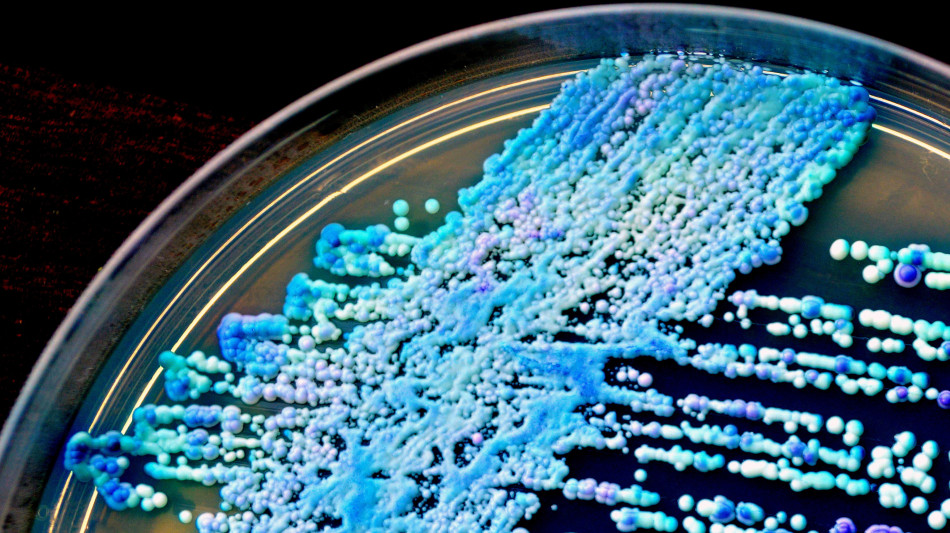
Scoperto un nuovo ceppo della Candida auris a Singapore

Scoperto un nuovo ceppo della Candida auris a Singapore
Un pericolo per i pazienti fragili soprattutto negli ospedali
Un team di ricercatori di Singapore ha individuato un nuovo ceppo del fungo Candida auris (C. auris), un patogeno altamente resistente e trasmissibile, solitamente associato a ambienti ospedalieri. Questa nuova variante, la sesta a livello globale, è stata scoperta in un paziente senza recenti viaggi all'estero, suggerendo una possibile diffusione locale. Il Candida auris rappresenta una seria minaccia per la salute pubblica, in particolare per i pazienti immunocompromessi. La sua capacità di resistere ai trattamenti antifungini e di diffondersi rapidamente negli ambienti ospedalieri lo rende particolarmente preoccupante. La scoperta di questo nuovo ceppo sottolinea l'importanza di una sorveglianza continua e di strategie di contenimento efficaci. I ricercatori stanno sviluppando strumenti di intelligenza artificiale per identificare precocemente nuovi ceppi e monitorare l'evoluzione di questo patogeno. L'Organizzazione Mondiale della Sanità (OMS) ha ufficialmente classificato la Candida auris come una delle più gravi minacce per la salute pubblica a livello globale nell'anno. Questa dichiarazione, avvenuta in seguito alla crescente diffusione del fungo resistente ai farmaci e alla sua capacità di provocare infezioni gravi, ha sottolineato l'urgenza di intensificare la ricerca e le misure di controllo a livello internazionale.
Z.al-Jawder--BT


